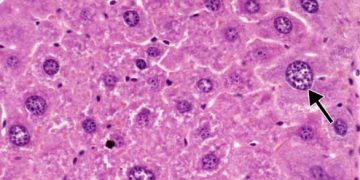
Hepatosit Nedir?

Hepatosit, karaciğerin temel işlevsel parankim hücresidir. Hepatocyte
Read moreDetailsVetRehberi, Veteriner Hekimlik mesleği, hayvan sağlığı, hayvan hastalıkları, hayvan beslenmesi, hayvan ırkları, ebooks, sözlük, veteriner ilaçlar, yaban hayatı hakkında içerik yayınlayan ve soru-cevap ile hayvanlarınızın sorunlarına cevap veren bilgi platformudur.